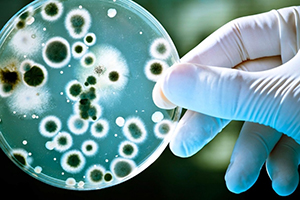

Осторожно бруцеллез !
ГБУ СО «СВО» Большеглушицкая СББЖ» информирует всех заинтересованных лиц о том, что по состоянию на текущую дату на территории Большеглушицкого района имеется 5 очагов по бруцеллезу крупного рогатого скота, 1 очаг по бруцеллезу лошадей.
Для того, чтобы не допустить дальнейшее распространение болезни и ликвидации эпизоотических очагов необходимо провести ряд мероприятий. В ближайшее время начнется бесплатная вакцинация животных против бруцеллеза.
Перед вакцинацией животных в данный момент начали проводить отбор проб крови крупного рогатого скота для серологического исследования на бруцеллез. Задача населения и владельцев животных- предоставить весь имеющий скот для проведения ветеринарно-
профилактических мероприятий. Но делать это необходимо в тесном взаимодействии всех, кто несет ответственность- органы власти, ветслужба и сами владельцы животных.
Лицам, содержащим скот в частных подворьях:
— администрации сельских поселений по хозяйственной книге производить регистрацию животных в ветеринарном учреждении;
покупку, продажу, сдачу на убой, выгон, размещение на пастбище и все другие перемещения проводить только с разрешения государственной ветеринарной службы;
— карантинировать в течение 30 дней вновь приобретенных животных для проведения ветеринарных исследований и обработок;
— информировать ветеринарную службу обо всех случаях заболеваний с подозрением на бруцеллез (аборты, рождение нежизнеспособного молодняка);
— строго соблюдать рекомендации ветеринарной службы по содержанию скота;
— администрации сельских поселений по хозяйственной книге производить регистрацию животных в ветеринарном учреждении;
покупку, продажу, сдачу на убой, выгон, размещение на пастбище и все другие перемещения проводить только с разрешения государственной ветеринарной службы;
— карантинировать в течение 30 дней вновь приобретенных животных для проведения ветеринарных исследований и обработок;
— информировать ветеринарную службу обо всех случаях заболеваний с подозрением на бруцеллез (аборты, рождение нежизнеспособного молодняка);
— строго соблюдать рекомендации ветеринарной службы по содержанию скота;
Населению:
— приобретать продукты животного происхождения в строго установленных местах (рынки, магазины, мини-маркеты и т. д.)
не допускать употребление сырого молока, приобретенного у частных лиц;
— при приготовлении мяса-готовить небольшими кусками, с проведением термической обработки не менее часа.
— приобретать продукты животного происхождения в строго установленных местах (рынки, магазины, мини-маркеты и т. д.)
не допускать употребление сырого молока, приобретенного у частных лиц;
— при приготовлении мяса-готовить небольшими кусками, с проведением термической обработки не менее часа.
Соблюдение указанных рекомендаций позволит предотвратить заражение бруцеллезом!
Главный ветврач «Большеглушицкой СББЖ» Цуканова Л.М